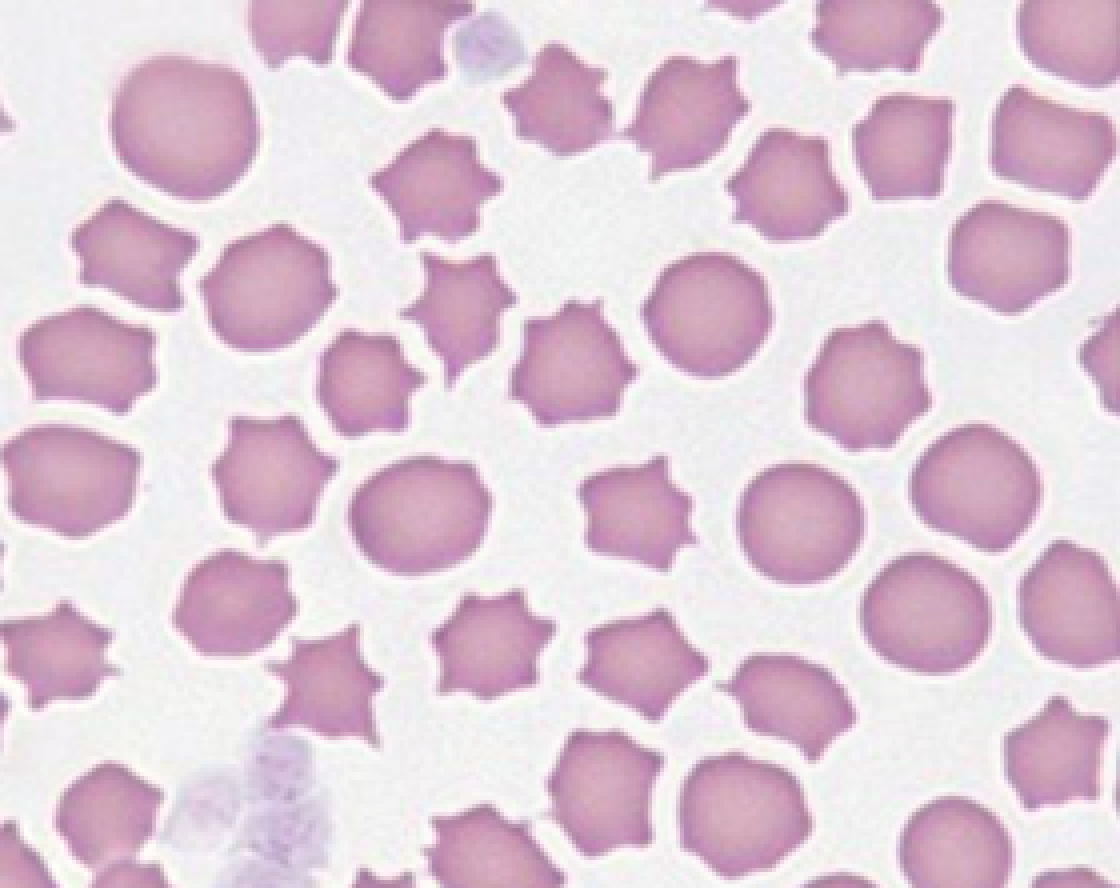
Cell classification animation

The Wolfram Solution for Biosciences

The Wolfram biological sciences solution offers a complete workflow—AI-enabled answering of high-level questions alongside the technology to get the answers out. Take raw data and model, analyze, publish and present it all in one place with the most automated development and deployment environment available.
From Messy Data to Usable Results
Computation is now center stage in biosciences. Wolfram delivers up-to-date, easy-to-use tools for computation and automation, so you can ask the same questions and get better results than ever before.
Import Your Data
Whether it's an Excel spreadsheet, microscope feed or bioacoustic recording, your data will work with Wolfram, without specialist programs. Immediately import from 150+ file formats.
Rethink Data Presentation
Showcase your results with interactive graphics, live demonstrations, blogs and slide shows. Effortlessly export reports and publications to PDF, CSV and XLS or as interactive notebook documents or websites to make them easy to reproduce and confirm.
“I’m a bioscientist, not a programmer.” With Wolfram, you’re both.
Our tools are made for beginner and expert programmers alike. Wolfram delivers the highest level of computation without compromising usability, so results are driven by your data, not your programming ability.
From Free-Form Input to Functional Code
Wolfram is your personal programmer. The AI assistant embedded in notebooks acts like a translator between you and your code. Type in your idea and watch the code flow out, immediately executable and editable.
Powerful Ease of Use
With its intuitive English-like function names and coherent design, Wolfram Language is uniquely easy to read, write and learn.
User-Friendly Documentation
Exploration made simple, with an easy-to-navigate library of all functions including how-to-use guides, inspiration and >50,000 interactive examples, all in one place.
Built-In Integration with Other Languages
Don't let limited software be the barrier between you and the answers in your data. No need to start from scratch—just import your Excel files or code from R or Python straight into Wolfram.
Built-In Computation & Data at All Scales
Computation at Every Scale
Specialist functions for everything from molecules to genome and protein sequences to living organisms to population dynamics.
- Life Sciences & Medicine: Data & Computations
- Molecular Structure & Computation
- Wolfram Chemistry
- Explore More
Up-to-Date Banks of Biological Data
Built-in, curated genomic, proteomic, anatomical, pharmaceutical and socioeconomic data, without the need to download endless packages.
Get Started
Access the Wolfram solution for biosciences through Wolfram|One or Mathematica.
Free Interactive Courses
Wolfram U offers courses, learning events and other resources from a range of computational fields. Build your knowledge of Wolfram Language and get certified by a world-recognized leader in technical innovation.
Advancing Biosciences with Wolfram
Watch this webinar to explore real-world examples and workflows—from retrieving genome/protein sequences and rendering interactive 3D biomolecule visualizations to applying image processing for cellular analysis and utilizing geocomputation for impactful data visualization—all without requiring external libraries.
Inject Ultimate Computation, Whichever Way You Want
Wolfram believes in the power of computation to deliver better results and decisions. Whether you need the technology to solve your problems or you require a full development consultation from our experts, we are here to help.
Programming Support
Having trouble getting your project to production? Whether you need advice, optimization for your existing code or simply additional resources, our experts are here to help.
Contact UsFull Project Development
Wondering how to use computation and AI to take your projects, big or small, to the next level? Our experts will help map out what's possible by understanding your goals, building on your domain knowledge and deploying an optimized solution—getting the most out of computation.
Wolfram ConsultingCore Technology
Wolfram's technology stack is the world's most extensive general computation platform. From data science to AI development, mathematical problems, system modeling and much more, use Wolfram tech to answer computational questions and easily build interactive applications.
Products & TechnologyEducation & Training
Improve your team's ability to get answers with computation with in-person training or ready-made learning materials and courses—whether you need assistance with a particular piece of Wolfram tech or broader domain-specific skills.
Contact Us